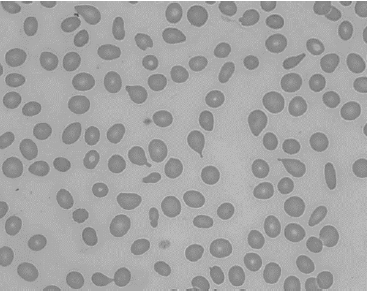
Enunciado 4537284-1

Foram encontradas 490 questões.
Entre as síndromes mielodisplásicas, aquela que tem a maior probabilidade de transformação para leucemia aguda é a
Provas
O esfregaço do sangue periférico mostrado abaixo refere-se a um paciente que apresenta anemia intensa (hemoglobina: 6 g/dL) e esplenomegalia.
O diagnóstico mais provável para o caso é
Provas
Em um paciente que apresenta dosagem de hemoglobina de 18,5 g/dL, sem outras leucocitoses e sem trombocitemia, assinale a afirmativa correta acerca do exame laboratorial que ajuda a diferenciar a policitemia vera da poliglobulia secundária.
Provas
O tratamento de base da talassemia beta major deve ser feito com transfusão seriada de concentrado de hemácias e luspatercept. Em relação ao luspatercept, o mecanismo de ação e o efeito clínico esperado são, respectivamente,
Provas
A respeito da deficiência da enzima Glicose 6-Fosfato Desidrogenase (G6PD), é correto afirmar que
Provas
O tratamento das anemias ferroprivas com reposição oral de ferro três vezes por dia, um comprimido 1/2 hora antes de cada refeição, pode levar a uma diminuição na absorção do ferro, reduzindo a resposta ao tratamento.
O mecanismo que explica esse efeito consiste em
Provas
O tratamento de escolha para os pacientes portadores de Leucemia Mieloide Crônica (LMC) é feito com inibidores de tirosino-quinase.
A respeito desse tipo de tratamento, e tendo-se em conta o que preconizam as diretrizes do SUS para o tratamento da LMC, assinale a afirmativa correta.
Provas
Uma paciente de 44 anos de idade é internada devido a AVC isquêmico, com alteração do nível da consciência. Seu hemograma mostra uma hemoglobina de 7,5 g/dL, com leucócitos normais e 5.000 plaquetas/\( μ \)L. Teste de Coombs direto negativo, ureia e creatinina normais.
No esfregaço do sangue periféricos há muitos esquizócitos; a contagem de reticulócitos é de 6% e a dosagem de LDH é de 1.581. Os níveis séricos de ADAMTS-13 estão muito baixos. Com esse quadro, pode-se afirmar que o paciente é portador de
Provas
Um paciente de 55 anos de idade abriu um quadro de mieloma múltiplo, do tipo IgG. Apresenta CKD-EPI de 40 mL/min/1,73 m2, hipercalcemia, anemia moderada (hemoglobina de 8 g/dL) lesões líticas em vértebras. Foi tratado com lenalidomida, bortezomibe e dexametasona, a que se seguiu um transplante autólogo de medula óssea.
O tratamento de manutenção desse paciente deve ser feito com
Provas
Um paciente de 21 anos, portador de doença falciforme, tipo SS, procura a emergência de um hospital com queixa de dor torácica e abdominal, de forte intensidade (9, na escala analógica da dor). Ele apresenta hipóxia, febre (38 ºC) e piora da anemia (hemoglobina: 4 g/dL). A tomografia de tórax mostra infiltrados pulmonares bilaterais. O paciente tem história prévia de síndrome de hiperhemólise.
Além de hidratação vigorosa, oxigênio e antibióticos, a conduta imediata a ser tomada deve incluir
Provas
Caderno Container